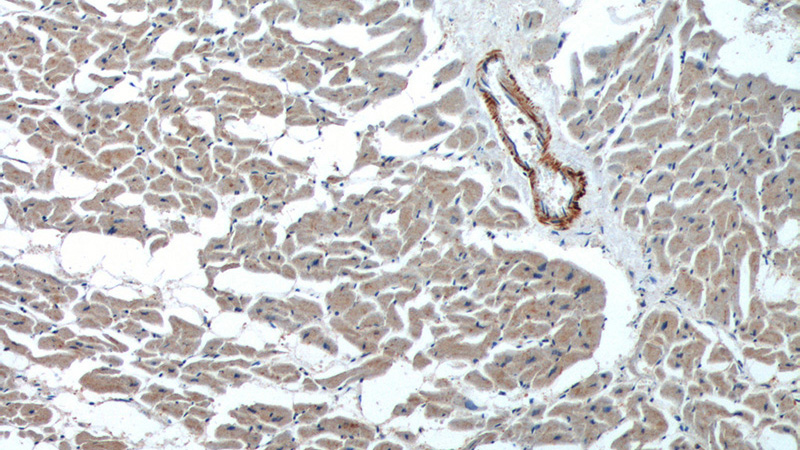
Immunohistochemistry of paraffin-embedded human heart tissue slide using Catalog No:113131(NAV1 Antibody) at dilution of 1:200 (under 10x lens).

-
Product Name
neuron navigator 1 antibody
- Documents
-
Description
neuron navigator 1 Rabbit Polyclonal antibody. Positive WB detected in mouse brain tissue. Positive IHC detected in human heart tissue, human placenta tissue, human skeletal muscle tissue. Observed molecular weight by Western-blot: 195-202 kDa
-
Tested applications
ELISA, WB, IHC
-
Species reactivity
Human,Mouse,Rat; other species not tested.
-
Alternative names
DKFZp781D0314 antibody; FLJ12560 antibody; FLJ14203 antibody; KIAA1151 antibody; KIAA1213 antibody; NAV1 antibody; neuron navigator 1 antibody; POMFIL3 antibody; steerin 1 antibody; STEERIN1 antibody; Unc 53 homolog 1 antibody; unc53H1 antibody
-
Isotype
Rabbit IgG
-
Preparation
This antibody was obtained by immunization of neuron navigator 1 recombinant protein (Accession Number: BC007523). Purification method: Antigen affinity purified.
-
Clonality
Polyclonal
-
Formulation
PBS with 0.02% sodium azide and 50% glycerol pH 7.3.
-
Storage instructions
Store at -20℃. DO NOT ALIQUOT
-
Applications
Recommended Dilution:
WB: 1:200-1:2000
IHC: 1:20-1:200
-
Validations

mouse brain tissue were subjected to SDS PAGE followed by western blot with Catalog No:113131(NAV1 antibody) at dilution of 1:500
Immunohistochemistry of paraffin-embedded human heart tissue slide using Catalog No:113131(NAV1 Antibody) at dilution of 1:200 (under 10x lens).

Immunohistochemistry of paraffin-embedded human heart tissue slide using Catalog No:113131(NAV1 Antibody) at dilution of 1:200 (under 40x lens).
-
Background
Neuron navigator 1 (NAV1) gene encodes a large protein belongs to the Nav/unc-53 family and 7 isoforms of NAV1 are produced by alternative splicing. NAV1 is localized in cytoplasm and expressed at high levels in heart, skeletal muscle and placenta, and especially in neuronal growth cones. Besides its nucleotide binding activity, NAV1 interacts with tubulin and associates with a subset of microtubule plus end, therefore playing a role in neuronal migration.
Related Products / Services
Please note: All products are "FOR RESEARCH USE ONLY AND ARE NOT INTENDED FOR DIAGNOSTIC OR THERAPEUTIC USE"
